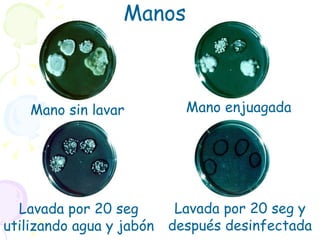
Mano sin lavar Mano enjuagada Lavada por 20 seg utilizando agua y jabón Lavada por 20 seg y después desinfectada Manos

El documento habla sobre las infecciones nosocomiales y las medidas de prevención, incluyendo la flora microbiana común en hospitales y la sensibilidad a antimicrobianos. Explica la técnica correcta para lavarse las manos, los momentos clave para hacerlo, y los productos usados para la higiene de manos como jabones, alcoholes y antisépticos. También discute la aceptación inadecuada de los protocolos de lavado de manos entre los trabajadores de la salud y cómo esto contribuye a la transmisión de